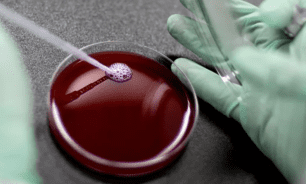
قريبا... تصنيع "سبوتنيك" في لبنان

قريبا... تصنيع "سبوتنيك" في لبنان
اعلن وزير الصناعة عماد حب الله بعد لقائه رئيس الجمهورية العماد ميشال عون الذي استقبله في قصر بعبدا قبل ظهر اليوم، أنه سيتم خلال الاسبوع الثاني من الشهر المقبل، توقيع عقد لتصنيع لقاح "سبوتنيك" في لبنان من خلال شركة "أروان" للصناعات الدوائية.
وأكد الوزير حب الله بحضور رئيس مجلس شركة "اروان" السيد عبد الرزاق يوسف، ونائبة رئيس الشركة الدكتورة رويدا دهام انه من خلال هذا العقد سيتم انتاج بين 30 و60 مليون لقاح سنوياً بإمكانات وكفاءات عالية على أن تبدأ الشركة بتصنيع هذا اللقاح فور وصول المواد الخام المستوردة من روسيا.
وتناول اللقاء بين الرئيس عون والوزير حب الله أزمة انتاج الاسمنت وقضية تصدير الصناعات اللبنانية الى السعودية ودول الخليج والخطوات الواجب اعتمادها لمعالجة هاتين المسألتين.
وبعد اللقاء تحدث الوزير حب الله الى الصحافيين فقال: "تشرفت بلقاء فخامة رئيس الجمهورية، وتم التباحث ببعض الامور التي تهم اللبنانيين، خصوصاً في ما يتعلق بالصناعة اللبنانية. واطلعنا الرئيس عون خلال الاجتماع على اخبار تحمل الطابع الايجابي في المجال الصناعي، وأخبار أخرى تتعلق ببعض الصعوبات التي نأمل ان تتذلل قريباً، لاسيما في ما يتعلق بمشكلة اقفال مصانع الترابة، وقد تم التواصل مع فخامة الرئيس ورئيس الحكومة في ما خص هذا الموضوع، ونأمل أن تحل الامور عبر اعطاء المصانع في لبنان الفرصة لفتح المقالع، كذلك على هذه المصانع في المقابل الالتزام بما وعدت به رئاسة الحكومة والوزراء. وتم الاتفاق على الاسعار بالنسبة للترابة وسنتمكن من الاعلان عنها قريباً عند فتح المقالع. ونؤكد أن هذه المشكلة ليست مشكلة وزارة الصناعة، بل تأخذ الوزارة هذه المشكلة على عاتقها للمساعدة في الوصول الى حل."
تابع:" وتناول اللقاء ايضاً قضية الصادرات اللبنانية الى المملكة العربية السعودية، حيث كان اتفاق تام مع فخامة الرئيس على الخطوات اللازمة التي على لبنان القيام بها، ونحن كحكومة لبنانية ملتزمة بتنفيذ كل ما يتطلبه هذا الموضوع لتأمين تصدير الصناعات اللبنانية الى المملكة والى دول الخليج بشكل ممتاز وبمراقبة تامة، مع التركيز طبعاً على موضوع اعتماد "السكانر" وما يجب القيام به في هذا المجال. وقد جرى البحث في إمكانية قيام وفد لبناني بزيارة الى المملكة العربية السعودية للتباحث في هذا الموضوع، وأعلنا جهوزيتنا للقيام بهذه الخطوة، ونتمنى من الاخوة في المملكة ان يتابعوا في تجاوبهم بالنسبة للصادرات اللبنانية إن كانت زراعية او صناعية."
وأضاف الوزير حب الله: "أما الخبر الايجابي الذي أحب أن أزفه الى اللبنانيين اليوم، بحضور السيد عبد الرزاق يوسف والدكتور رويدا دهام من شركة "اروان" للصناعات الدوائية، هو انه خلال الاسبوع الثاني من الشهر المقبل، سيتم توقيع عقد لتصنيع لقاح "سبوتنيك" في لبنان من خلال شركة "أروان". ونشكر الشركة على اندفاعها والكفاءة الموجودة لديها وجهدها للوصول الى هذه النتيجة، وقد طلبنا من فخامة الرئيس دعمه لهذا المشروع، وكان طبعا ًمن الداعمين لنا منذ الانطلاقة الاولى، وقد عبّر ودولة الرئيس دياب عن استعدادهما للقيام بما يلزم لتسهيل الامور. ونحن نتطلع الى يوم التوقيع على هذه الاتفاقية، وإن شاء الله تكون بادرة خير، حيث ستنتج الشركة بين 30 و60 مليون لقاح سنوياً، بإمكانات وكفاءات عالية.
وأهنئ الصناعة اللبنانية على كل ما تقدمه، خصوصا خلال فترة كورونا، وأتوجه بالتهنئة ايضاً الى شركة "اروان " والى مجلس ادارتها وعمالها وموظفيها على هذا الانجاز الذي نأمل أن يتحقق قريبا من دون اي عقبات، واتوجه بالتهنئة الى الاستاذ يوسف والدكتورة دهام على جهودهما لتحقيق هذا المشروع، وستقدم وزارة الصناعة كل الدعم لنجاحه".
سئل: متى يبدأ التصنيع الفعلي للقاح؟
أجاب الاستاذ عبد الرزاق يوسف: "نشكر فخامة الرئيس الجمهورية على دعمه اللامحدود كما دولة رئيس مجلس الوزراء، وإن شاء الله سنبدأ خلال فترة لا تزيد عن الشهرين بالانتاج والتصنيع، ويعتمد ذلك على تاريخ استلام المواد الاولية من روسيا، لأننا نصنع المستحضر بناء على المواد الخام المستوردة من روسيا، ونبشر بأن الوضع جيد، وإن شاء الله نزف الخبر الجيد خلال اسبوعين من الآن."
سئل الوزير حب الله عن حل مشكلة الترابة والتوازن في الاسعار، أجاب: "أريد التـأكيد على أننا قلنا سابقاً أننا سنضبط التصدير، فتم ضبطه، وقلنا اننا سنسمح بالاستيراد، وفتحنا باب الاستيراد واصدرنا تراخيص لذلك، أما بالنسبة الى الاسعار فقد تم التوافق مع الشركات ومع الوزراء المختصين بهذا الموضوع على سعر يعتبر ممتاز بالنسبة للصناعة المحلية والفارق بينها وبين المستورد من الخارج. ونأمل أن يتم حل هذا الموضوع قريباً خصوصاً أن الناس بأشد الحاجة الى ذلك في الوقت الراهن."
واستقبل الرئيس عون رئيس المجلس الدستوري القاضي طنوس مشلب وعرض معه عمل المجلس في ضوء حالة الشغور التي يعاني منها بعد وفاة ثلاثة من أعضائه، إضافة الى قضايا قانونية ودستورية.